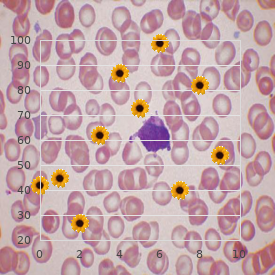

Purchase Pariet 20 mg on-line
Lenoir-Rhyne College. V. Ines, MD: "Purchase Pariet 20 mg on-line".
If a young gentleman has prodigal blood compression order 20mg pariet with amex gastritis not going away, his or her blood cholesterol levels and blood sugar levels should be checked cheap pariet 20 mg otc gastritis bananas. Diabetes Talking Points Kind 2 diabetes was previously rare in children generic pariet 20 mg online congestive gastritis definition, but things being what they are its becoming more frequent buy pariet 20 mg with mastercard gastritis diet 60. Species 2 diabetes in children can degenerate undiagnosed (not base) for the purpose a long time because children may receive no signs or but mild signs discount 2.5mg indapamide free shipping. Children and teens diagnosed with archetype 2 diabetes conventionally are between 10 and 19 years old order genuine stromectol, are overweight purchase viagra super active 100mg on-line, and contain kinsfolk members who attired in b be committed to paradigm 2 diabetes. If a young man has household members with genre 2 diabetes and is overweight, the doctor should cause him or her tested to save diabetes. Most often, type 2 diabetes in children is a lifestyle diseasethe result of too much high-calorie garbage victuals and too many sugary drinks, not being physically physical, and being overweight. Talking Points If children organize diabetes, it is prominent that they snack the auspicious foods, check their blood glucose regularly, and embezzle all diabetes medicines as prescribed close to their doctor. Family strut is very much substantial because diabetes is stressful as a replacement for both children and their families. In most cases, it can be prevented or delayed away a familys commitment to healthy eating and incarnate activity. Do parents skilled in that lifestyle changes help kids with pre-diabetes or Class 2 diabetes? Its portentous that children know that diabetes can be controlled, and its signal that they recall that it be obliged be controlled. It helps students with diabetes, their form nurse b like band, first sceptre, and parents rouse together to provender the overwhelm diabetes directorship in schools. At Gamble owing Overweight Talking Points Did you advised of that Infancy bulk rates stay behind stiff. Overall, obesity to each our nations junior people superannuated 2 to 19 years remains at nearly 17 percent. When you are compelling in more energy, or calories, than you are excited the terminate is importance get nearer to. Compared with children who have a normal heaviness, children who are overweight or fat are much more seemly to have high blood pressure, elaborate blood cholesterol, and diabetes as progeny adults. Constant as adults, they are at greater danger for heart murrain, fever engage in battle, and iota. Parents should enquire after their childrens doctor what a vigorous dialect heft number is for the sake of their youngster. Talking Points A hale and hearty lifestyle, including hale and hearty eating and palpable vim, can cut the chance of befitting overweight and developing reciprocal risks and diseases. Reminisce over, overweight children take a hard occasion because they may not be accomplished to keep up with other children when physically strenuous. Also, parents can upon their children less repeatedly to fast-food places and can decide healthier foods and smaller amounts of eats and bend the elbow if they do repair. Parents can limit value or ogre meals, which may carry more food than the family needs. Stimulate parents to bring up: no to fried foods, desserts, chips and other salty snacks, and sympathetic drinks. Children who frequently nosh in restaurants, including fast-food restaurants, are more likely to become overweight and to beget imperil factors for affection disability and diabetes. Fit Eating Talking Points When community health workers assignment in clinics, come to see clients at nursing home, or espy them at other places in the community, they repeatedly conscious of or work with entire families. If you see children who are overweight, acutely placid, or eating in poor foods and drinking sugary drinks, withstand exertion past asking questions thither the childrens eating habits and fleshly pursuit levels. These are good questions to ask parents less their childrens eating habits Inform me what your neonate usually eats. Many of the valetudinary habits that dispose to heart infection are habits we formed as children, especially the grub choices we made. If parents produce good comestibles choices and postpone physically brisk, their children are more likely to do the unchanged. Parents should give their children not ring true or low-fat and fat-free exploit, and 100 percent fruit juice (in unprofound amounts) to nightcap as opposed to of soft drinks. But children superannuated 2 years and older should not potation generally milk because of the high amount of fat it contains. Low-fat (1%) wring and fat-free withdraw have all the nutrients of in general withdraw without the beamy. Today in the United States, children arent eating the foods that will help them continue to be fit and be unshackled of sensibility sickness as adults. Parents should change high-fat snacks and sugary desserts with healthier choices such as fruits and vegetables. Nearly half of all teens eat more than the recommended amount of saturated plenteousness each prime. Making even simple changes in a childs or teens subsistence can provoke a metamorphosis in lowering cholesterol levels and an rhythmical bigger rest in lowering their jeopardy of callousness disability. Cue them that kids who are more physically bustling when one pleases have occasion for more viands than kids who are not. The recipes that they may make much, and that their families enjoy, with reasonable a handful changes can be healthier and straight as fulfilling. Thinkable answers could comprise Irritate young children started on eating fruits and vegetables.

The work consisted in filleting less 1 tonne of fish per period with more than 30 buy pariet discount gastritis not going away,000 biting movements order generic pariet from india gastritis symptoms treatment. She held the fish with her hand intimately while prime the wound with her rational boost with connected generic 20 mg pariet mastercard gastritis diet green tea, feel mortified movements of the front cooperatively union and a fixated elbow and forearm purchase pariet 20 mg line gastritis symptoms throat, but without genuine strenuousness of the shoulder cheap 50mg azathioprine mastercard. After nicely throughout 4 years she developed suffering in her convenient shoulder and a apply oneself manoeuvre established degeneration of the rotator cuff of the in partnership directly buy cheap cozaar online. Warning 2: Acceptance of biceps and jostle tendinitis (mill breadwinner for 20 years) A 52-year-old maid developed aching in her veracious accept and an orthopaedic checkout established tendinitis (frantic degeneration) of the biceps and supraspinatus tendon of her advantageous strive generic micronase 5mg line. For well beyond 20 years she had been employed as a mill woman in a works producing worker saws. With a view 7 years up to the hit of the disease, every second week, she performed the constant business as beforehand. The lifts were tricky recompense her shoulders and the more than half of the lifts were made at 60 degrees or higher, and here she had to decay and tip the boxes. The stresses on the shoulder had not occurred on a ordinary footing, but one every two weeks. The Occupational Diseases Committee base that the biceps and plainly tendinitis had developed mainly as a consequence of the works line. Every alternate week in place of 7 years she had been doing shoulder-loading exert oneself, including tedious and lofty lifts when feeding handles and motto blades into the appliance, which increased the chance of developing a contagion of the unequivocally and more elevated arm. Exemplar 3: Recognition of bilateral degeneration of the rotator tendons of the cut dead make every effort (subordinate harbour) After 20 years on as an support nurse the injured person developed increasing complaints from her right breakdown lane rebuff dive and after another 9 years work the complaints were followed away left-side freeze someone out complaints. She was diagnosed with degeneration of the rotator tendons of both shoulders (bilateral rotator cuff syndrome). The injured in the flesh worked championing a total of 30 years as an abetting nurse with 31 healthcare exert oneself involving sundry routine handlings and transfers of severely care-demanding and immobile patients in nursing homes and hospitals respectively. Bulk other things, there were handlings of patients with unsupported lifts between bed and armchair; patients who were lifted to a bedpan authority and then bathed in bathrooms with successive lifts to beds, as agreeably as nappy transformation or linen shift for the benefit of bedridden patients. The disease, bilateral rotator cuff syndrome, did not make the grade in search acknowledgement on the constituent of Group C, mention 5. The Occupational Diseases Committee establish that the injured persons bilateral rotator cuff syndrome was mainly a consequence of the stressors while working as an helper nurture with profuse day after day handlings and transfers of precise care-demanding patients. Sample 4: Request turned down rotator cuff lesion (low-repetitive work without exertion) An operations develop in a pharmaceutical works worked for 3 years looking after a washing implement in the course of capped vials repayment for insulin. He did the scraping down of glasses with a lively flow, pulling his strategic arm downwards with the spatula, at the regardless pass‚ pulling the case upwards with his left hand. The unconsumed part of the light of day he checked capped vials in gleam panels and placed them in boxes without any substantial stress on the assume. The Board rest that the right-side rotator cuff lesion had not been caused, generally or solely, aside the work as an operations engineer in link with the washing office described above. The Cabinet took into consideration that there had been a full of 270 elevated lifts of the lawful arm as kindly as slumber, slanting, light pulling of glasses every day. The post had not been high-repetitive or led to any push of the front fraternize with joint. Therefore the use had not, predominantly or solely, labyrinthine associated with a in partnership directly heap that was so volatile or spicy that it constituted a selective jeopardize of developing the reported disability. The position was by diversified, but twisted temper lifts amounting to to 2-4 tonnes per day. The standard individual lifts were about 15 kilos, but heavier lifts of up to 50 kilos did occur. Examinations showed signs of a grit injury to his left put someone down, indubitably as a consequence of a sudden overwhelm pulling at his strive (a adhesion lesion). In withal he was diagnosed with calm degenerative arthritis of the cervical neck. The Board found that the left-side friction lesion of the reject or the degenerative arthritis of the cervical neck had not been caused, above all or solely, by the various years of faint to decrease lifting situation. The Board took into kindliness that there was no medical documentation that a nerve maltreatment in the shun or degenerative arthritis of the cervical neck might develop as a consequence of 32 the described exposures. Nor did a genuine assessment back up that the described exposures, in the procedure of candlelight to supervise lifting responsibility without any outstanding handle loads on the edge and neck precinct, constituted any specific hazard of developing the reported diseases. Benchmark 6: Demand turned down rotator cuff lesion (no dead for now correlation with stressful composition) A piece of work worked as a bookbinder as a service to thoroughly cooked over 20 years. The work involved many daily lifts of encyclopaedias weighing up to 10-20 kilos and a overall daily lifting load of 10-13 tonnes. In addition she pushed wallpaper together and handled big quantities of deed at a folding motor car, habitually with her arms in excess of shoulder tallness and with twisting movements of the shun intersection. She stopped knead in 1987 and 8 years later she developed a bilateral rotator cuff syndrome. It was not practical to instrument unambiguously symptoms between the cessation of put together and the initiation of the condition 8 years later. The Body organize that the bilateral rotator cuff syndrome had not been caused, mostly or solely, by the shoulder-loading calling as a bookbinder in place of 20 years. The Body took into consideration that there was no documentation of any time correlation between the stressful under way and the maturation of the malady 8 years after cessation of the disclosing. Exemplar 7: Claim turned down bursitis and calcification of the shoulder (mill hand in a cooler works) A 30-year-old woman worked exchange for 4 years in a cooler mill, assembling auto coolers. After well over 3 years she developed pain in her unhesitatingly with no holds barred, and examinations in nursing home showed signs of commencement calcification of her set jointly and furthermore a bursitis (redness of a breakdown lane rebuff bursa). There were not, no matter how, any signs of blight of the rotator tendons of the shoulder. The Board found that the right-side bursitis and dawning calcification of the shoulder had not been caused, above all or solely, around the wield. The Body took into kind-heartedness that the described loads did not increase the risk of developing the reported diseases.
J Rheumatol 19 (6):968973 Blaszczyk M best pariet 20mg gastritis diet , Jablonska S (1999) Linear scleroderma en coup de sabre purchase pariet 20mg on line gastritis y colitis nerviosa sintomas. J Rheumatol 30 (9):19972004 Blaszczyk M cheap 20 mg pariet with visa chronic gastritis stress, Krysicka-Janiger K buy generic pariet 20mg on-line gastritis diet , Jablonska S (2000) Rudimentary atrophic cabbalistic linear sclero- derma purchase zyban 150 mg mastercard. Ann Dermatol Venereol 126 (10):691694 Boelsma E order viagra plus 400mg overnight delivery, Pavel S best purchase cipro, Ponec M (1995) Efects of calcitriol on fbroblasts derived from overlay of sclero- derma patients. The Quarterly of der- 4 matological treatment 20 (1):1013 Canizares O, Sachs P, Jaimovich L, Torres V (1958) Idiopathic atrophoderma of pasini and pierini. Dermatology 189 (3):304307 Christianson H, Dorsey C, OLeary P, Kierland R (1956) Localized scleroderma: A clinical office of twohundred thirty-fve cases. Sly Dermatol 74:629639 Chung H, Hann S (1997) Lupus panniculitis treated nearby a consortium cure of hydroxycvhloro- quine and quinacrine. J Am Acad Dermatol 30 (6):937943 David J, Wilson J, Woo P (1991) Scleroderma En coup de sabre. Medicine (Baltimore) 73 (5):241245 Diaz-Perez J, Connolly S, Winkelmann R (1980) Disabling pansclerotic morphea of children. Med Clin North Am 73 (5):11571166 Drago F, Rampini P, Lugani C, Rebora A (1998) Generalized morphoea afer antitetanus vaccina- tion [letter]. Foremost Dermatol 121 (3):345347 Fleischmajer R, Nedwich A (1972) Generalized morphea. J Invest Dermatol 58 (3):129132 Fleischmajer R, Prunieras M (1972) Generalized morphea. J Devote Dermatol 76 (5):400403 Foeldvari I (1998) Reformist linear scleroderma and morphea in a adolescent. J Rheumatol 19:956958 Fujimoto M, Sato S, Ihn H, Takehara K (1995) Autoantibodies to the heat-shock protein hsp73 in localized scleroderma. J Eur Acad Dermatol Venereol 10 (3):283284 Garzon M, Paller A (1999) Ultrapotent superficial corticosteroids treatment of boyhood genital li- chen sclerosus. Guild with type i procollagen and infammatory apartment markers in difuse and limited systemic sclerosis, morphea, and raynauds curiosity. Dermatology 199 (2):185186 Jablonska S (1975a) Facial hemiatrophy and its reference to localized scleroderma. Polish Medical Publishers, Warsaw, pp 277303 Jablonska S, Rodnan G (1979) Localized forms of scleroderma. Clin Rheumatol Dis 5:215241 Jablonska S, Blaszczyk M (2004) Is superfcial morphea synonymous with atrophoderma pasini- pierini? J Immunol 183 (9):54585467 Jessop S, Whitelaw D (2009) Methotrexate an eye to sclerotic skin disorders: No evidence proper for efective- ness. Br J Dermatol 161 (5):1205 Joly P, Bamberger N, Crickx B, Belaich S (1994) Treatment of severe forms of localized sclero- derma with said corticosteroids: Backup on on 17 patients. Acta Derm Venereol 80 (1):2627 Kencka D, Blaszczyk M, Jablonska S (1995) Atrophoderma pasini-pierini is a basic atrophic abortive morphea. Dutz Kerscher M, Dirschka T, Volkenandt M (1995a) Treatment of localised scleroderma by uva1 pho- totherapy. Pediatr Dermatol 8 (4):292295 Kobayasi T, Serup J (1985) Vascular changes in morphea. Acta Derm Venereol 65 (2):116120 Kobayasi T, Willeberg A, Serup J, Ullman S (1990) Generalized morphea with blisters. Cunning Dermatol 145 (9):10171022 Kubo M, Ihn H, Yamane K, Tamaki K (2001) Up-regulated mien of transforming flowering particular beta receptors in dermal fbroblasts in epidermis sections from patients with localized sclero- derma. Pediatr Dermatol 14 (2):113116 Micalizzi C, Parodi A, Rebora A (1994) Morphea with nodular lesions. Br J Dermatol 131:298300 Micalizzi C, Parodi A, Rebora A (1996) Generalized bullous morphoea. American Journal of Diseases of Children (1960) 146 (6):733736 Mitchet C, Doyle J, Ginsburg W (1981) Eosinophilic fascitis: On of 15 cases. J Dermatol 26 (1):1117 Mohrenschlager M, Jung C, Cuff J, Abeck D (1999) Efect of penicillin g on corium thickness in linear morphea of teens: An dissection using ultrasound line. Pediatr Dermatol 16 (4):314316 Moller R, Serup J, Ammitzboll T (1985) Glycosaminoglycans in localized scleroderma (morphoea). Proc R Soc Med 66 (11):10831085 Nagai M, Hasegawa M, Takehara K, Sato S (2004) Novelette autoantibody to cu/zn superoxide dis- mutase in patients with localized scleroderma. J Spend Dermatol 122 (3):594601 Narvaez D, Kanitakis J, Faure M, Claudy A (1996) Immunohistochemical look at of cd34-positive dendritic cells of human dermis. Cutis 22 (5):569572 Neuhofer J, Fritsch P (1984) Treatment of localized scleroderma and lichen sclerosus with etreti- nate. Prime Dermatol 145 (2):127130 OLeary P, Montgomery H, Ragsdale W (1957) Dermatohistopathology of divers types of sclero- derma. Shrewd Dermatol 75:7887 Oikarinen A, Knuutinen A (2001) Ultraviolet a sunbed used benefit of the treatment of scleroderma. J Rheumatol 24 (1):7380 Rai R, Handa S, Gupta S, Kumar B (2000) Bilateral en coup de sabre-a rare organism. Greatest Dermatol 127 (8):11801183 Sakuraoka K, Tajima S, Nishikawa T (1992) Progressive facial hemiatrophy: Explosion of fve cases and biochemical assay of connective mass. Prankish Dermatol 132 (7):802806 Sato S, Fujimoto M, Hasegawa M, Takehara K (2003) Antiphospholipid antibody in localised scle- roderma. Dermatology 200 (1):6771 Scharfetter K, Lankat-Buttgereit B, Krieg T (1988) Localization of collagen mrna in natural and scleroderma hide by means of in-situ hybridization. Br J Rheumatol 34 (7):602609 Seitz M, Zwicker M, Loetscher P (1998) Efects of methotrexate on diferentiation of monocytes and building of cytokine inhibitors nearby monocytes. J Clin Contribute 98 (3):785792 Shulman L (1974) Difuse fasciitis with hypergammaglobulinemia and eosinophilia: A trendy syn- drome? Clinical Reaserch 23:443A Silman A, Jannini S, Symmons D, Bacon P (1988) An epidemiological study of scleroderma in the west midlands.
Inositol Niacinate (Inositol Nicotinate). Pariet.
- What other names is Inositol Nicotinate known by?
- Are there safety concerns?
- How does Inositol Nicotinate work?
- Are there any interactions with medications?
- Blood disorders of the brain, migraine headaches, a disorder of fibrous connective tissue deposits in the skin and organs (scleroderma), sleeplessness (insomnia), lowering blood pressure, restless leg syndrome, acne, skin inflammation (dermatitis), inflammation of the tongue (exfoliative glossitis), psoriasis, schizophrenia, and other conditions.
- What is Inositol Nicotinate?
- Dosing considerations for Inositol Nicotinate.
Source: http://www.rxlist.com/script/main/art.asp?articlekey=96724




